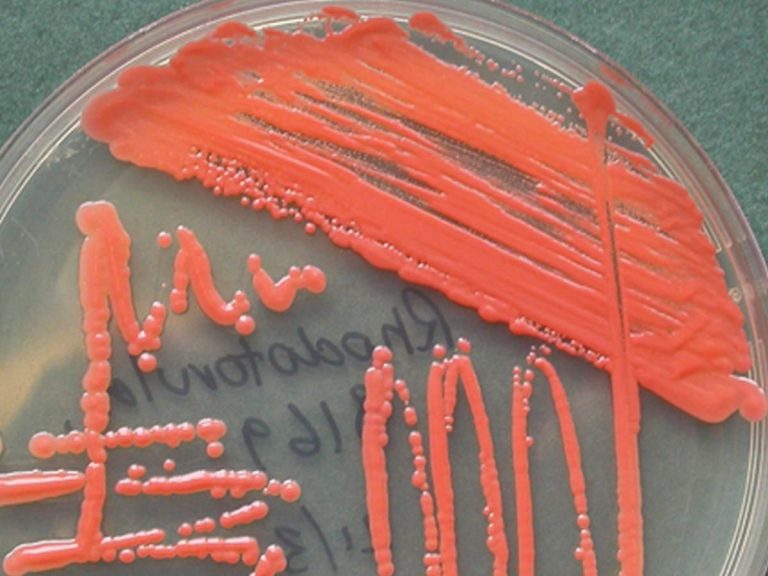

Rhodotorula rubra fungus

Родоторула рубра мөөгөнцрийн халдвар (монгол)
Грибок Rhodotorula rubra (ру́сский)
Product usage indication and contraindication
Хэрэглэх, эс хэрэглэх бүтээгдэхүүнүүд
Родоторула рубра мөөгөнцрийн халдвар (монгол)
Грибок Rhodotorula rubra (ру́сский)
Хэрэглэх, эс хэрэглэх бүтээгдэхүүнүүд